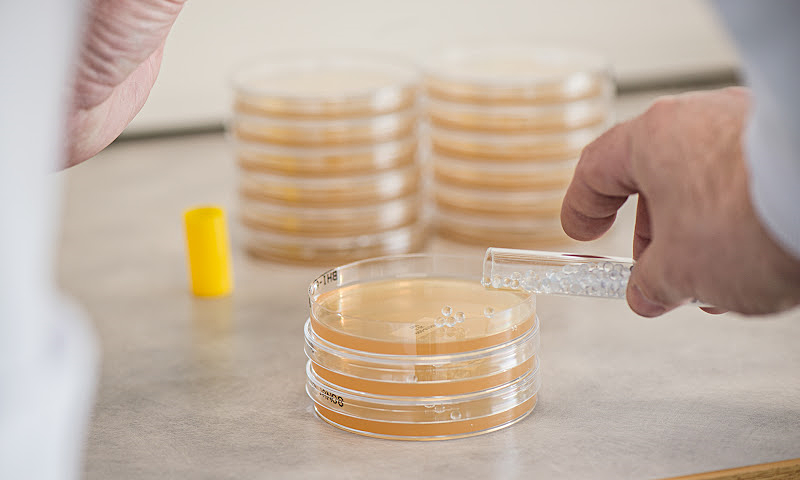

Thực phẩm bảo vệ sức khỏe BioGaia Protectis chứa chủng L.reuteri DSM 17938 được nghiên cứu lâm sàng, chứng minh hỗ trợ cải thiện rối loạn tiêu hóa, tăng cường miễn dịch cho trẻ sơ sinh và trẻ nhỏ.
Năm 2025 đánh dấu cột mốc 10 năm hiện diện của BioGaia – thương hiệu men vi sinh đến từ Thụy Điển. Trong suốt thập kỷ qua, doanh nghiệp cho biết đã đồng hành cùng đội ngũ bác sĩ, dược sĩ và hàng triệu phụ huynh Việt Nam trong hành trình chăm sóc sức khỏe đường ruột cho trẻ sơ sinh và trẻ nhỏ.
Chủng L. reuteri DSM 17938, được bảo hộ toàn cầu bởi tập đoàn BioGaia AB Thụy Điển, cũng là thành phần chính trong sản phẩm BioGaia Protectis Baby Drops, được khuyến cáo bởi các Tổ chức Y khoa hàng đầu trên Thế giới như Tổ chức Tiêu hóa Thế giới (WGO), Hiệp hội Tiêu hóa, Gan mật và Dinh dưỡng Nhi khoa châu Âu (ESPGHAN).

Sản phẩm BioGaia Protectis Baby Drops. Ảnh: BioVagen
Mới đây, tại lễ kỷ niệm 10 năm BioGaia tại Việt Nam, PGS.TS Nguyễn Thị Việt Hà, Trưởng Khoa Tiêu hóa, Bệnh viện Nhi Trung ương, đã nhấn mạnh tầm quan trọng của hệ vi sinh đường ruột trong việc duy trì sức khỏe toàn diện, đặc biệt ở trẻ sơ sinh.

PGS.TS Nguyễn Thị Việt Hà phát biểu tại lễ kỷ niệm 10 năm BioGaia tại Việt Nam. Ảnh: BioVagen
Theo PGS.TS Việt Hà, cơ thể mỗi người tồn tại khoảng 100 nghìn tỷ vi khuẩn, tạo nên một hệ vi sinh vật độc nhất. Không chỉ ảnh hưởng đến tiêu hóa, hệ vi sinh đường ruột còn liên quan mật thiết tới hệ miễn dịch của con người, khi 70% tế bào miễn dịch tập trung ở ruột. Điều này lý giải vì sao người ta cho rằng có tới 90% bệnh tật đều ít nhiều có liên quan đến sức khỏe đường ruột.
Ở trẻ sơ sinh, giai đoạn đầu đời chính là thời điểm then chốt để định hình hệ vi sinh đường ruột khỏe mạnh. Sữa mẹ luôn được xem là nguồn dinh dưỡng tối ưu, giúp hệ vi sinh của bé phát triển cân bằng. Trong đó, chủng lợi khuẩn L.reuteri DSM 17938 có nguồn gốc từ sữa mẹ, đã được nghiên cứu lâm sàng trên 183 nghiên cứu, chứng minh có thể đem lại nhiều lợi ích cho sức khỏe của trẻ. Chủng lợi khuẩn này được xem là bước tiến khoa học quan trọng, cho thấy hiệu quả trong cải thiện các rối loạn tiêu hóa chức năng, đặc biệt là hội chứng colic (khóc dạ đề) ở trẻ sơ sinh.
Sáu thử nghiệm lâm sàng ngẫu nhiên có đối chứng đã chứng minh việc bổ sung lợi khuẩn này giúp rút ngắn đáng kể thời gian khóc trong ngày, đồng thời tăng tỷ lệ đáp ứng điều trị. Không chỉ vậy, L. reuteri DSM 17938 cũng là chủng lợi khuẩn được khuyến cáo ở cả việc dự phòng và kiểm soát tình trạng khóc dạ đề, theo khuyến nghị của Tổ chức Tiêu hóa Thế giới (WGO).
Bên cạnh đó, chủng lợi khuẩn này còn cho thấy hiệu quả đối với các rối loạn tiêu hóa chức năng khác như trào ngược dạ dày – thực quản và táo bón chức năng.

Môi trường nuôi cấy lợi khuẩn L. reuteri DSM 17938 trong phòng thí nghiệm của BioGaia AB Thụy Điển. Ảnh: BioGaia Group
Theo dữ liệu công bố trên Jama Network, sau ba tháng bổ sung L. reuteri DSM 17938, trẻ có thời gian khóc trung bình mỗi ngày khoảng 38 phút, thấp hơn đáng kể so với 71 phút ở nhóm sử dụng giả dược. Số lần trào ngược trung bình giảm từ 4,6 xuống còn 2,9 lần một ngày, trong khi số lần đi tiêu tăng từ 3,6 lên 4,2 lần một ngày.
Đại diện BioGaia Việt Nam cho rằng, những bằng chứng khoa học này cho thấy việc can thiệp sớm bằng lợi khuẩn an toàn có thể giúp rút ngắn thời gian chịu đựng các triệu chứng, thay vì chỉ chờ tự khỏi như quan điểm trước đây. Điều này không chỉ mang lại lợi ích trực tiếp cho trẻ, mà còn giảm gánh nặng tinh thần và tài chính cho gia đình, đồng thời hỗ trợ giảm tải cho hệ thống y tế.
Thế Đan